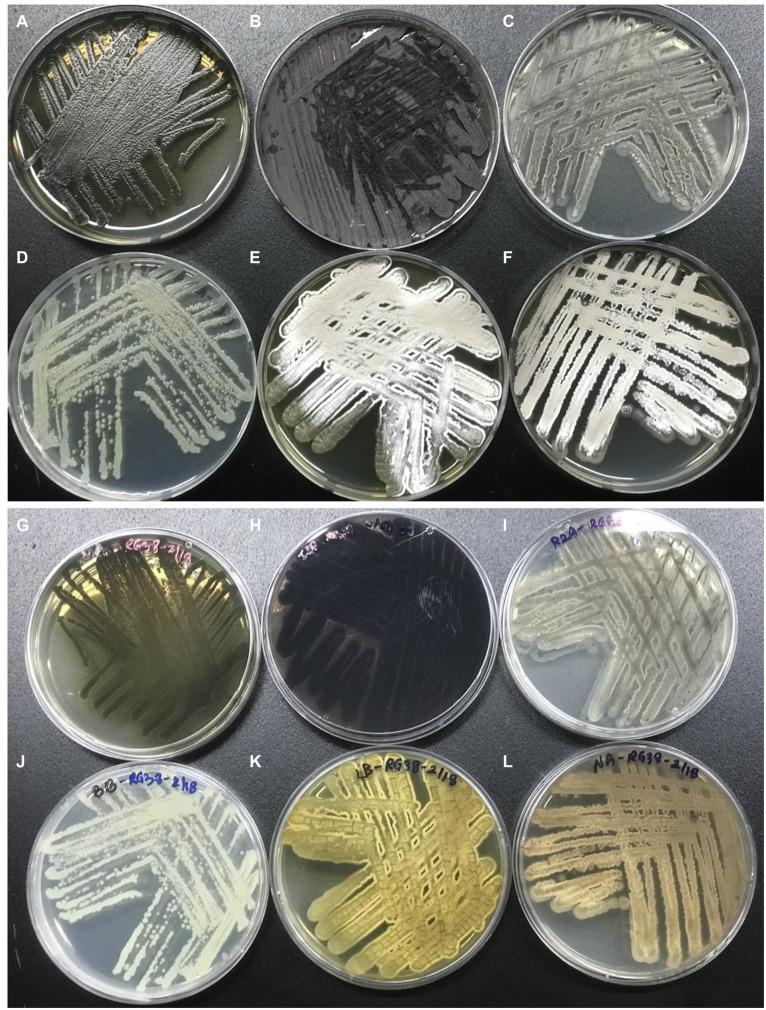

新种,一种从……根部分离出的产色霉素细菌。 (原文句子不完整,翻译可能不太准确,完整准确的翻译需结合完整原文)
sp. nov., a chromomycin producing bacteria isolated from the roots of .
作者信息
Chhetri Geeta, Kim Myeong Ji, Kim Inhyup, Tran Duc V H, Kim Young-Woo, Kim Hyun Woo, Seo Taegun
机构信息
Department of Life Science, Dongguk University-Seoul, Goyang, Republic of Korea.
College of Pharmacy and Integrated Research Institute for Drug Development, Dongguk University-Seoul, Goyang, Republic of Korea.
出版信息
Front Microbiol. 2024 Mar 1;15:1361583. doi: 10.3389/fmicb.2024.1361583. eCollection 2024.
A novel halotolerant actinobacterium, designated as RG38, capable of producing black extracellular melanin pigment on SP2 agar, was isolated from the roots of . Comparative analysis of the 16S rRNA gene sequence revealed the highest similarity to NBRC 12759 (99.3%). Phylogenetic analysis showed that strain RG38 clustered within the genus forming a monophyletic cluster with its close relatives. The average nucleotide identity (ANI), digital DNA-DNA hybridization (dDDH), and amino-acid identity (AAI) values between strain RG38 and related species within the genus were below the standard threshold for prokaryotic species delineation. The DNA G + C content of the strain RG38 was determined to be 73.3%. The genome size measured 7,150,598 bp comprising 17 contigs and encompassed 6,053 protein coding genes. AntiSMASH analysis of the whole genome revealed 35 putative biosynthetic gene clusters (BGCs) responsible for various secondary metabolites. Among these clusters, two gene clusters exhibited 100% similarity to the chromomycin A3, albaflavenone, and anthracimycin, respectively. These compounds were reported to possess significant anticancer and antibacterial activities. LC-MS-based analysis, coupled with further isolation studies, confirmed the production of chromomycins A2 (1), A3 (2), and their derivatives, along with their antibiotic activities. These findings underscore the potential of this novel strain as a novel resource for the discovery of diverse antimicrobial compounds. This study is the first to report an antimicrobial compound producing species isolated from medicinal plant . Based on a polyphasic study, the strain RG38 isolated from an unexplored habitat with a high potential for new natural products represents a novel species within the genus . Accordingly, we propose the name sp. nov. for this novel species, with the type strain is RG38 (=KCTC 49624 = TBRC 15113).
从……的根部分离出一种新型耐盐放线菌,命名为RG38,它能够在SP2琼脂上产生黑色细胞外黑色素。16S rRNA基因序列的比较分析显示,它与NBRC 12759的相似度最高(99.3%)。系统发育分析表明,菌株RG38聚集在该属内,与其近亲形成一个单系簇。菌株RG38与该属内相关物种之间的平均核苷酸同一性(ANI)、数字DNA-DNA杂交(dDDH)和氨基酸同一性(AAI)值均低于原核生物物种划分的标准阈值。菌株RG38的DNA G + C含量测定为73.3%。基因组大小为7,150,598 bp,由17个重叠群组成,包含6,053个蛋白质编码基因。对整个基因组的抗SMASH分析揭示了35个负责各种次生代谢产物的假定生物合成基因簇(BGC)。在这些簇中,两个基因簇分别与嗜铬霉素A3、白黄青霉素和炭疽霉素表现出100%的相似性。据报道,这些化合物具有显著的抗癌和抗菌活性。基于液相色谱-质谱的分析以及进一步的分离研究,证实了嗜铬霉素A2(1)、A3(2)及其衍生物的产生及其抗菌活性。这些发现突出了这种新型菌株作为发现多种抗菌化合物新资源的潜力。本研究首次报道了从药用植物……中分离出的一种产生抗菌化合物的……物种。基于多相研究,从具有新天然产物高潜力的未开发栖息地分离出的菌株RG38代表了该属内的一个新物种。因此,我们为这个新物种提议命名为……sp. nov.,模式菌株为RG38(=KCTC 49624 = TBRC 15113)。